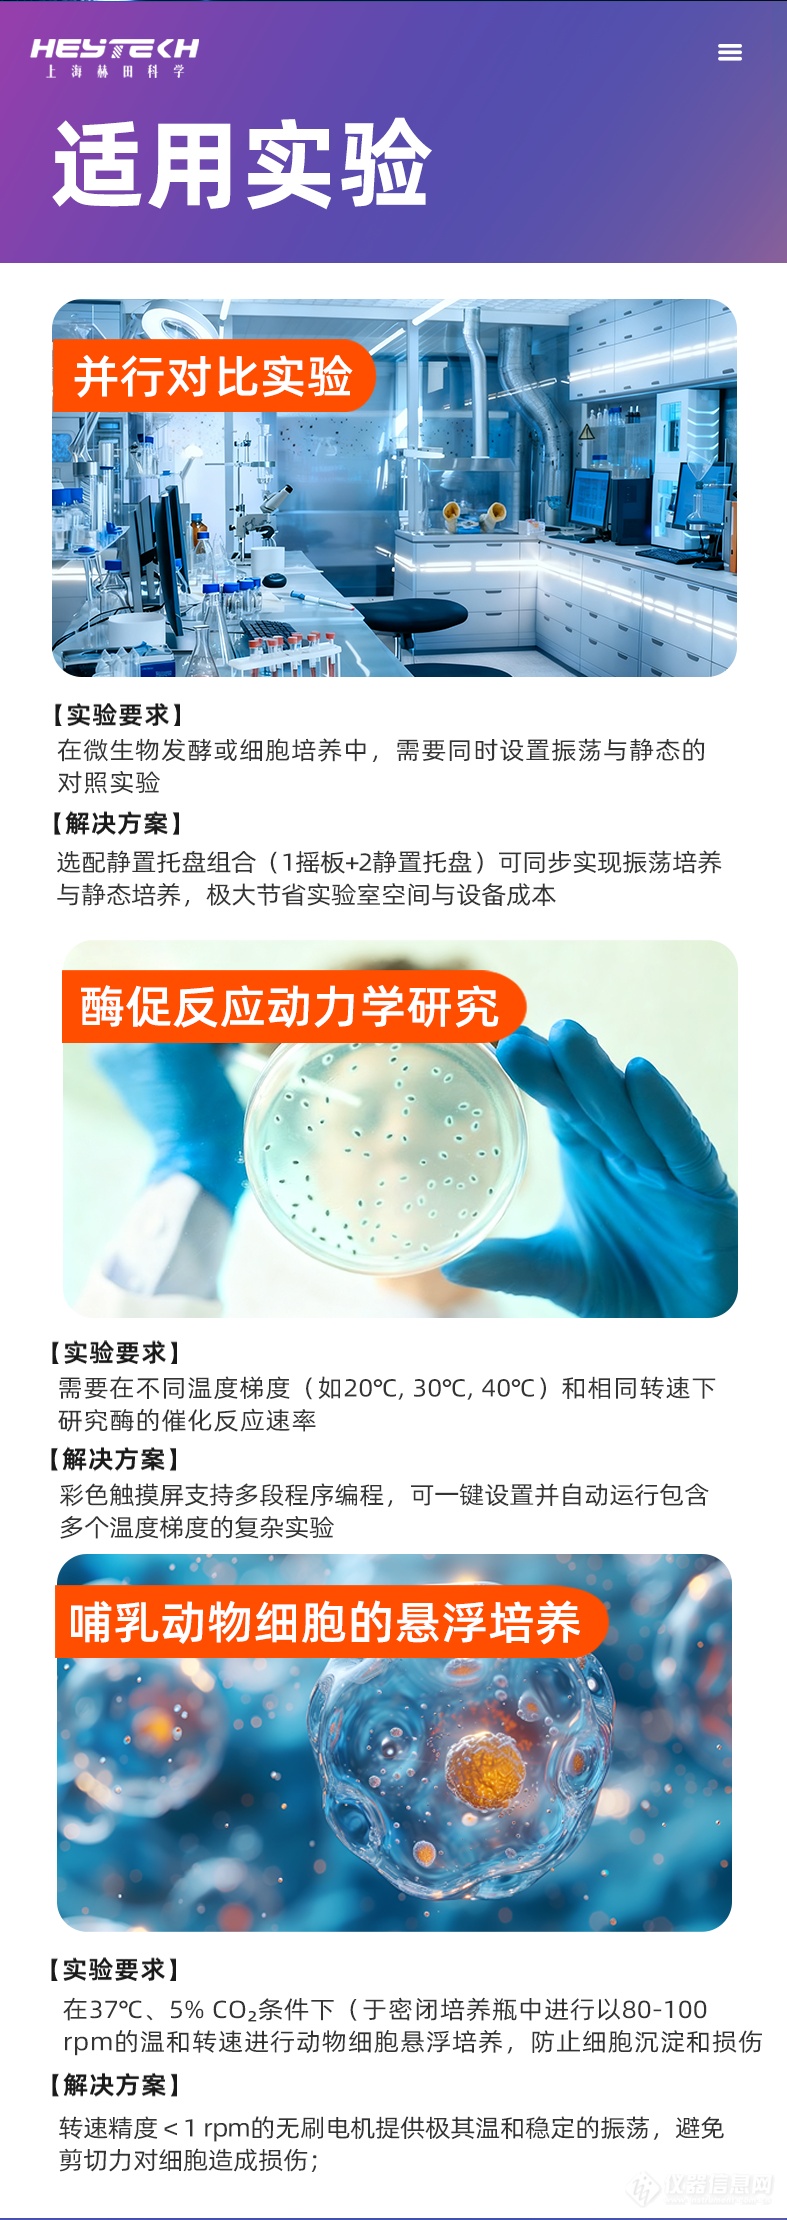

搜索
品牌:上海赫田/Herrytech
产地:上海
型号:YQ-A300
400-616-7676转2666
核心参数
仪器介绍








核心参数一览:专业性能,一目了然
为了让您快速了解YQ-A300的核心性能,我们将关键参数整理如下:
参数项目 | 详细规格 |
型号 | YQ-A300 立式 |
振荡平台 | 两层,尺寸 390×290mm |
最大容量 | 100ml×36支 / 250ml×24支 / 500ml×16支 (灵活适配) |
温控范围 | 4~60℃ (兼具加热与制冷功能) |
温控精度 | ±0.5℃ |
转速范围 | 30~300 rpm |
转速精度 | ±1 rpm |
摆振幅度 | φ26mm (标配回旋振荡,可选往复) |
定时范围 | 0~999小时/分钟 (满足长时实验需求) |
内容积 | 150L |
标配夹具 | 万能弹簧夹具 × 2层 |

YQ-A200 立式恒温摇床:以高性价比,满足您多样化的培养与振荡需求
(专业可靠的实验室多功能振荡培养解决方案)
摘要: YQ-A300 立式恒温摇床(亦称振荡培养箱),集恒温、振荡、培养功能于一体。其精准的温控(4-60℃±0.5℃)与稳定的转速(30-300rpm±1rpm),适用于细胞培养、微生物发酵、生化反应等多种实验。150L大容量内胆与灵活的多层摇板设计,提供了出色的样品处理能力。支持选配光照、CO2;及加湿功能,是高校实验室、质检部门等高性价比的理想选择。
为什么YQ-A300是您实验室的高性价比之选?
1. 精准稳定的温控系统,保障实验重现性
YQ-A200提供从4℃至60℃的宽范围温度控制,意味着您不仅能进行常规的微生物振荡培养,还能完成对温度敏感的低温生化培养(如在4℃下保存某些菌种或酶)。±0.5℃的高精度确保了箱体内温度均匀稳定,为实验结果的重现性与可靠性奠定了坚实基础。
2. 强劲均匀的振荡效果,提升培养效率
采用精密的驱动系统,转速范围覆盖30-300rpm,精度可达±1rpm。结合φ26mm的标准摆振幅度,能为培养物提供充分且温和的混匀与氧气供给。无论是细菌发酵还是细胞悬浮培养,都能获得一致、高效的振荡效果。
3. 灵活高效的空间利用与样品处理能力
立式设计: 占地面积小,为紧凑的实验室空间节省了宝贵的地面面积。
150L大内胆: 内部高度达700mm,提供了充裕的操作空间。
双层振荡平台: 标配两层摇板,可同时容纳多达36个100ml三角瓶,显著提升批量实验效率。
4. 人性化操作与持久耐用设计
999小时长效定时: 无需人工值守,自动完成长时间振荡培养任务。
万能弹簧夹具: 标配夹具兼容多种规格的培养瓶、三角瓶,安装便捷,固定牢靠。
功能扩展:轻松升级为全能型振荡培养箱
YQ-A300的强大之处在于其模块化设计,您可以根据未来的实验需求,选配以下功能模块,实现设备价值的最大化:
选配1:静置培养架
可将一层摇板更换为2-3层静置培养架,实现“振荡”与“静置” 培养模式的自由切换,一机多用。
选配2:光照培养功能 (0~30000LX)
升级为光照培养箱,适用于藻类培养、植物组织培养、种子发芽、育苗等需要精确光照控制的实验领域。
选配3:CO2;浓度控制 (0~20%)
配合红外传感器,实现精确的二氧化碳环境控制,专为细胞培养和某些藻类培养实验设计,提供理想的生长环境。
选配4:主动加湿功能
有效防止培养液蒸发,对于需要长时间培养或对湿度敏感的实验至关重要。
选配5:手机远程控制
实现远程监控与操控,随时掌握实验进程,提升科研效率与便捷性。
结语
YQ-A300立式恒温摇床不仅仅是一台仪器,更是一个可靠、灵活的实验平台。它以其核心的精准控制、出色的性价比和强大的功能扩展性,致力于成为您实验室中不可或缺的得力助手。无论是基础的微生物振荡培养,还是进阶的细胞、藻类研究,它都能提供强有力的支持。
立即咨询,了解这款高性价比立式恒温摇床如何助力您的科研工作!
拨打电话
留言咨询